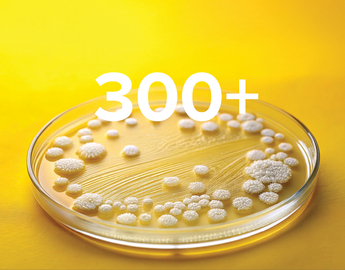
300+ active research projects

About UCVM
Serving the veterinary, animal, and public health needs of Alberta and beyond.
The University of Calgary Faculty of Veterinary Medicine (UCVM), Alberta’s only veterinary school, has been addressing the province's need for skilled veterinary professionals since its inception in 2005.
Recognized globally for its pioneering curriculum and hands-on clinical training, UCVM operates on a unique distributive model, partnering with private practices and organizations to provide DVM students with workplace-based learning opportunities. UCVM offers a comprehensive DVM program, Graduate degrees (MSc, PhD), and specialized clinical training (internships, fellowships, residencies).

Home to North America’s biggest outdoor classroom!
Home to North America’s biggest outdoor classroom! W.A. Ranches offers unparalleled hands-on learning and research opportunities, shaping the future of livestock health and sustainable agriculture.